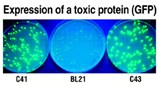

High Efficiency Expression Of Toxic Proteins

OverExpress C41(DE3) and C43(DE3) Competent Cells allow expression of a wide variety of toxic proteins previously difficult or impossible to express in bacteria, including most membrane proteins, some cytoplasmic proteins, and nucleases. These cells provide a direct alternative to BL21(DE3) in expressing any gene cloned into a plasmid containing the T7 promoter. More than 350 publications have validated the effectiveness of OverExpress C41(DE3) and C43(DE3) strains in expressing toxic and membrane proteins from viruses, eubacteria, archaea, yeasts, plants, insects, and mammals. The OverExpress strains are available exclusively from Lucigen in the US and Canada as high efficiency electrocompetent and chemically competent cells.
SOURCE: Lucigen Corporation